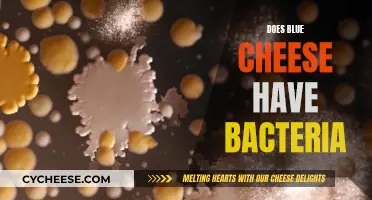
Blue Cheese and Bacteria: A Tasty Combination?

Blue cheese is a generic term for several varieties of cheese, including Gorgonzola, Stilton, and Roquefort, each with its own unique flavour, texture, aroma, and appearance. It is a fermented cheese made using Penicillium Roqueforti mold cultures and is known for its bold flavour and pungent smell. While blue cheese is high in sodium, it is also a good source of protein, calcium, potassium, phosphorus, zinc, vitamin A, vitamin B12, and vitamin D. However, it is unclear whether blue cheese contains iron.
Explore related products
What You'll Learn
- Blue cheese is a good source of vitamin B12, protein, calcium, phosphorus, potassium, vitamin A, and vitamin D
- It is high in sodium, so should be consumed in moderation
- Blue cheese is made using the mold Penicillium roqueforti
- It is safe for human consumption and is available in reduced-fat and reduced-sodium varieties
- Blue cheese may help lower the risk of cardiovascular disease and arthritis

Blue cheese is a good source of vitamin B12, protein, calcium, phosphorus, potassium, vitamin A, and vitamin D
Blue cheese is a nutrient-dense food that offers a variety of health benefits. It is particularly rich in vitamin B12, a vitamin that the human body cannot produce and must be sourced from food or supplements. Vitamin B12 is essential for folate metabolism, which assists in repairing DNA damage and may have cancer-protective properties. Blue cheese is also a good source of protein, with dairy proteins being more easily absorbed by the body than those from beef or fish.
In addition to vitamin B12 and protein, blue cheese contains a significant amount of calcium. Calcium is vital for maintaining bone density and strength, and blue cheese provides 10% of the recommended daily calcium intake. The calcium in blue cheese may also be linked to anti-obesity mechanisms that help reduce body weight from fat and manage levels of visceral fat around the abdomen. However, it is important to note that calcium absorption can be enhanced by pairing blue cheese with vitamin D-rich foods, as blue cheese contains less than 1% of the recommended daily vitamin D intake.
Blue cheese also contains phosphorus, which is important for healthy bones and plays a role in muscle contraction and nerve impulse transmission. Additionally, it is a source of potassium, which is beneficial for controlling blood pressure. The presence of these minerals, along with the compound spermidine, may contribute to the positive effects of blue cheese on cardiovascular health.
While blue cheese offers these nutritional benefits, it is important to consume it in moderation due to its high-fat content, particularly saturated fat, which can increase the risk of heart disease if consumed in excess. Blue cheese is also high in sodium, which should be considered by individuals with high blood pressure or those on a low-sodium diet.
Blu Cheese and Tyramine: What's the Connection?
You may want to see also

It is high in sodium, so should be consumed in moderation
Blue cheese is a nutrient-dense food that offers a variety of health benefits. It is an excellent source of vitamin B12, providing 21% of the daily value per 1.5-ounce serving. It is also rich in protein, calcium, phosphorus, potassium, zinc, vitamin A, vitamin D, vitamin K2, and antioxidants.
However, blue cheese is high in sodium, so it should be consumed in moderation. The 2020-2025 Dietary Guidelines for Americans recommend that people over 14 years of age consume no more than 2,300 mg of sodium per day. Those with high blood pressure or on a low-sodium diet should be mindful of their blue cheese intake to stay within the recommended daily sodium limit.
While blue cheese has a bold and tangy flavor that enhances many dishes, its high sodium content can be detrimental to individuals with high blood pressure. Sodium intake is linked to increased water retention, which can elevate blood pressure. For this reason, it is crucial for individuals with hypertension to monitor their sodium consumption and choose low-sodium options or consume blue cheese in moderation.
Additionally, blue cheese is high in calories and fat, particularly saturated fat, which can increase the risk of heart disease if consumed in excess. Therefore, those following a low-calorie or low-fat diet should limit their intake of blue cheese or opt for reduced-fat varieties.
In conclusion, blue cheese offers numerous nutritional benefits, but its high sodium, calorie, and fat content warrant moderation in consumption. Individuals with specific health concerns, such as high blood pressure or dietary restrictions, should be particularly mindful of their blue cheese intake to maintain a balanced and healthy diet.
Blue Cheese: Friend or Foe to Infection?
You may want to see also

Blue cheese is made using the mold Penicillium roqueforti
Blue cheese is made using the mould Penicillium roqueforti. This mould is what gives blue cheese its distinctive blue veins, bold flavour, and pungent smell. The mould grows within small punctures created on top of the cheese loaves at the beginning of the cheese ripening process.
Penicillium roqueforti is a species of mould that is enormously diverse and is found not only in many distinct blue cheeses but also across the food world and the natural world. It is a frequent source of spoilage of cereal products, especially rye bread, commonly preserved with weak acids in Europe. It is also unusually tolerant of sorbic acid, which it degrades to produce a kerosene taint.
Blue cheese is made by mixing Penicillium roqueforti mould spores with milk to begin the fermentation process. After the cheese forms into a solid shape, cheesemakers pierce it with stainless steel needles to create pathways for air to flow. This process results in the distinctive blue veins of blue cheese.
Penicillium roqueforti has an active metabolism that breaks down protein and fat very effectively. This yields the textures, aromas, and flavours characteristic of blue cheese. The mould produces both proteolytic and lipolytic enzymes, which soften the curd and produce the desired body in the cheese. The water-soluble lipases produced by this fungus hydrolyze milk fats to free fatty acids, such as butyric, caprylic, caproic, and capric acids, which all contribute to the flavour of blue cheese.
The Blue Cheese of Roquefort: A Distinctive Delicacy
You may want to see also
Explore related products

It is safe for human consumption and is available in reduced-fat and reduced-sodium varieties
Blue cheese is safe for human consumption, but it is recommended that it be consumed in moderation due to its high fat, calorie, and sodium content. It is also advised that people with certain allergies, especially those allergic to mold or with sensitivities to dairy products, avoid blue cheese. For pregnant women, blue cheese made from unpasteurized milk is generally not recommended due to the risk of foodborne illnesses.
Blue cheese is available in reduced-fat and reduced-sodium varieties. The nutritional content of blue cheese varies depending on the type of milk used and whether the fat has been removed. For example, reduced-fat blue cheese contains 80 calories per ounce (28 grams) and 5 grams of fat.
Blue cheese is a nutrient-dense food that provides a variety of health benefits. It is an excellent source of vitamin B12, protein, calcium, monounsaturated fatty acids, vitamin B5, conjugated linoleic acid, phosphorus, and vitamin B2. It also contains a compound known as spermidine, which has been linked to a reduced risk of cardiovascular disease and potential anti-aging effects.
In addition to its nutritional benefits, blue cheese is a versatile ingredient that can enhance a variety of dishes. It can be added to salads, used as a pizza topping, included in wraps or omelets, or paired with various types of meat, nuts, or fruits on a charcuterie board.
While blue cheese offers these potential health benefits, it is important to remember that it should be consumed in moderation as part of a balanced diet.
Blue Cheese Unveiled: The Science Behind Its Veins
You may want to see also

Blue cheese may help lower the risk of cardiovascular disease and arthritis
Blue cheese is a nutrient-dense food that contains a variety of vitamins, minerals, and natural compounds that are beneficial to health. It is rich in dietary fats, protein, calcium, phosphorous, potassium, zinc, vitamin A, vitamin B12, and vitamin D. Blue cheese also contains a compound known as spermidine, which has been linked to a reduced risk of cardiovascular disease.
Several studies have found that consuming blue cheese may help lower the risk of cardiovascular disease. The protein in blue cheese, especially Roquefort, helps lower cholesterol levels, prevent artery inflammation, and prevent blood clotting in veins or arteries, thereby reducing the risk of cardiovascular diseases. Additionally, the presence of spermidine in blue cheese is believed to have a positive effect on cardiac muscle cells and other parts of the cardiovascular system. This may contribute to the "'French paradox," where lower rates of cardiovascular death are observed in France despite higher consumption of saturated fat.
The anti-inflammatory properties of blue cheese are also noteworthy. These properties can help reduce joint inflammation and ease arthritis pain. The calcium content in blue cheese is essential for bone health, contributing to bone density and strength, and may also be linked to anti-obesity mechanisms by reducing visceral fat around the abdominal area.
However, it is important to consume blue cheese in moderation due to its high-fat content, particularly saturated fat, which can raise cholesterol levels and negatively affect heart health if consumed in excess. Blue cheese is also high in sodium, which can be a concern for individuals with high blood pressure. Overall, blue cheese can be part of a healthy diet when consumed in moderation, offering potential benefits for cardiovascular health, arthritis, and bone strength.
Blue Cheese and Pinot Noir: A Match Made in Heaven?
You may want to see also
Frequently asked questions
No, blue cheese does not contain iron. However, it is a good source of calcium, vitamin B12, protein, phosphorus, potassium, vitamin A, and vitamin D.
Blue cheese has been linked to several health benefits, including improved bone health, dental health, and heart health. It also contains anti-inflammatory properties and may help reduce the risk of cardiovascular disease. Additionally, blue cheese is a good option for those following a gluten-free diet.
Yes, blue cheese is high in sodium, fat, and calories, so it should be consumed in moderation. It may also trigger allergic reactions in individuals with mold allergies or sensitivities to dairy products. Pregnant women should also exercise caution when consuming blue cheese, especially if it is made from unpasteurized milk.